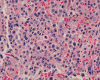
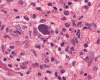

|
 |
OU Pathology
NeuroLearn
For
Medical Students & Residents
Department of Pathology,
University of Oklahoma Health Sciences Center, Oklahoma
City, OK, U.S.A.

This program is intended
only for educational purposes and not for diagnostic, research, or
therapeutic purposes. Copy rights reserved.
|
|
Neural: Tumor
Neural: Non-Tumor
Neuroanatomy Slides
Anatomic Pathology
Case of the Month
|
Neuropathology Quizzes

NQ-001 |

NQ-002 |

NQ-003 |

NQ-004 |

NQ-005 |

NQ-006 |

NQ-007 |

NQ-008 |

NQ-009 |

NQ-010 |

NQ-011 |

NQ-012 |

NQ-013 |

NQ-014 |

NQ-015 |

NQ-016 |

NQ-017 |

NQ-018 |

NQ-019 |

NQ-020 |

NQ-021 |

NQ-022 |

NQ-023 |

NQ-024 |

NQ-025 |

NQ-026 |

NQ-027 |

NQ-028 |

NQ-029 |

NQ-030 |

NQ-031 |

NQ-032 |

NQ-033 |

NQ-034 |

NQ-035 |

NQ-036 |

NQ-037 |

NQ-038 |

NQ-039 |

NQ-040 |

NQ-041 |

NQ-042 |

NQ-043 |

NQ-044 |

NQ-045 |

NQ-046 |
NQ-047 |

NQ-048 |

NQ-049 |

NQ-050 |

NQ-051 |

NQ-052 |

NQ-053 |

NQ-054 |

NQ-055 |

NQ-056 |

NQ-057 |

NQ-058 |
 NQ-059 |

NQ-060 |

NQ-061 |

NQ-062 |

NQ-063 |

NQ-064 |

NQ-065 |

NQ-066 |

NQ-067 |

NQ-068 |

NQ-069 |

NQ-070 |

NQ-071 |

NQ-072 |

NQ-073 |

NQ-074 |

NQ-075 |

NQ-076 |

NQ-077 |

NQ-078 |

NQ-079 |

NQ-080 |

NQ-081 |

NQ-082 |

NQ-083 |

NQ-084 |

NQ-085 |

NQ-086 |
NQ-087 |

NQ-088 |

NQ-089 |

NQ-090 |

NQ-091 |

NQ-092 |

NQ-093 |

NQ-094 |

NQ-095 |

NQ-096 |
NQ-097 |

NQ-098 |

NQ-099 |

NQ-100 |

NQ-101 |

NQ-102 |

NQ-103 |

NQ-104 |

NQ-105 |

NQ-106 |

NQ-107 |

NQ-108 |

NQ-109 |

NQ-110 |

NQ-111 |

NQ-112 |

NQ-113 |

NQ-114 |

NQ-115 |

NQ-116 |

NQ-117 |

NQ-118 |

NQ-119 |

NQ-120 |

NQ-121 |

NQ-122 |

NQ-123 |

NQ-124 |

NQ-125 |

NQ-126 |

NQ-127 |

NQ-128 |

NQ-129 |

NQ-130 |

NQ-131 |

NQ-132 |

NQ-133 |

NQ-134 |

NQ-135 |

NQ-136 |

NQ-137 |

NQ-138 |

NQ-139 |

NQ-140 |
|